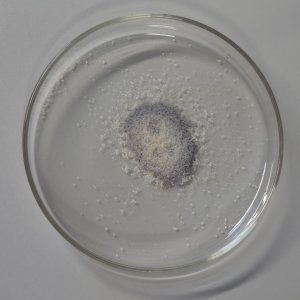

|
Experiment des Monats
|
Kleber ist ein Gemisch aus Proteinen (ca. 90%), Lipiden und Kohlenhydraten. Nur Mehle mit einem ausreichenden Klebergehalt können zu Brotlaiben verbacken werden (andernfalls sind nur Fladen möglich), da der Kleber im wesentlichen das Gashaltevermögen bestimmt und für die lockere Krume verantwortlich ist.
|
 |
Geräte und Chemikalien:
Hartweizengries, 0,5%ige alkoholische Ninhydrin-Lösung, Bechergläser,
Tropfpipette, Heizplatte
Durchführung:
Eine kleine Probe trockenen Hartweizengries mit Ninhydrin-Lösung befeuchten (in einem Becherglas, Abdampfschale etc.)
und auf einer Heizplatte erwärmen. Es tritt eine intensive blauviolette Färbung auf.
Eine frische Probe Gries mit reichlich Wasser einige Minuten kochen und überstehende Lösung und unlöslichen
Bodensatz (vorher etwas ausspülen) mit Ninhydrin-Lösung versetzen. Nur die Lösung zeigt eine deutliche Farbänderung.
Erklärung:
Getreide besteht zum größten Teil aus Stärke (lösliche Amylose und unlösliches Amylopektin).
Je nach Getreideart und Ausmahlgrad variiert der Kleberanteil, bei den meisten Weizensorten liegt er um 10% der
Trockensubstanz. Der Kleber besteht wiederum überwiegend aus dem Protein Gluten.
Im trockenen Mehl bzw. Gries lassen sich daher Proteine nachweisen (z.B. mit der
Ninhydrin-Reaktion  EdM 09/2000).
EdM 09/2000).
Gluten ist in der Hitze relativ gut wasserlöslich.
Bei Kochen löst sich das Gluten weitgehend, zurück bleibt nahezu reines Amylopektin.
Hinweis: Man schätzt, dass in Deutschland zwischen 100.000 und 200.000 Menschen eine Veranlagung für die
Zöliakie haben. Diese entwickeln meist eine Unverträglichkeit gegen Glutene (die unterschiedlich stark
ausgeprägt sein kann). Es treten dann entzündlich-degenerative Darmveränderungen auf, die zu schweren
Verdauungsstörungen führen können.
Literatur & Links:
diverse Experimentierbücher, u.a. von Georg Schwedt
Römpp Lexikon Lebensmittelchemie
 zurück zum aktuellen Experiment
zurück zum aktuellen Experiment
Seite erstellt am: Donnerstag, 21. Dezember 2017,
A. Schunk,
Charité - Universitätsmedizin Berlin.
Für den Inhalt externer Seiten wird keine Verantwortung übernommen!